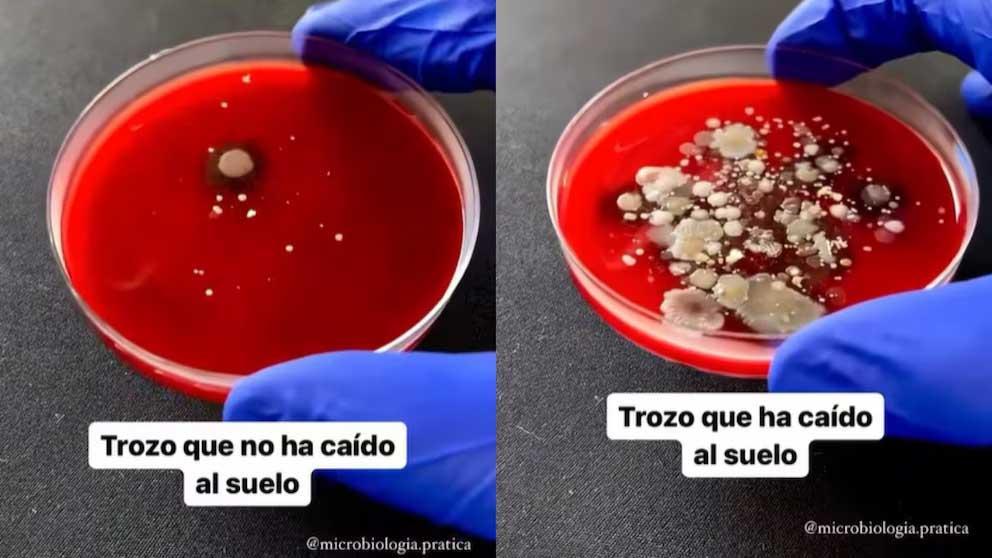

Escuchá esta nota
EL DIARIO digital
minutos
La llamada "regla de los tres segundos" es una creencia popular muy arraigada que sugiere que los alimentos que caen al suelo se mantienen seguros si se recogen antes de que transcurran esos pocos segundos. Sin embargo, a pesar de su sencillez, esta norma genera dudas desde la perspectiva científica.
Teresa Arnandis, doctora en Biomedicina y Bioquímica, profesora, investigadora y divulgadora científica, explicó que es posible comprobar experimentalmente hasta qué punto esta regla "es un mito o tiene algo de realidad".
El experimento contundente en placa Petri
En un video publicado en su cuenta de Instagram (@ladyscienceofficial), la biomédica, basándose en un experimento del microbiólogo Bruno Brunetti, observó si el alimento se contamina realmente aun siendo recogido con rapidez.
Para la prueba, se utiliza un trozo de comida que ha tocado el suelo por solo unos segundos y se lo coloca sobre una placa Petri con agar, un medio gelatinoso que permite el crecimiento y la visibilidad de bacterias. Para comparar, se usa otro trozo de comida que no ha tocado la superficie.
"Después de dejarlos incubando a 37 grados [temperatura similar a la del cuerpo humano], podemos observar que el que ha caído forma gran cantidad de colonias bacterianas, mientras que el que no ha caído al suelo apenas contiene contaminación bacteriana", explica Arnandis.
El resultado del experimento es contundente: incluso un contacto breve con el suelo basta para que se produzca transferencia bacteriana.
Factores que sí determinan la contaminación
La transferencia de microorganismos ocurre porque las superficies, aunque parezcan limpias, suelen albergar una gran cantidad de bacterias procedentes del polvo, el ambiente o el tránsito de personas. Estudios microbiológicos han demostrado que esta transferencia es prácticamente inmediata y que el tiempo de exposición influye menos de lo que se cree.
Lo que realmente determina la magnitud de la contaminación son factores como:
La textura del alimento: un alimento húmedo o pegajoso (como una fresa o pan con mantequilla) atraerá más microorganismos que otro más seco o duro (como una galleta o una nuez).
La humedad de la superficie.
La cantidad de bacterias presentes en el suelo.
La regla de los tres segundos ha perdurado por su componente cultural, como una forma de evitar desperdiciar comida. Sin embargo, el experimento recuerda que la contaminación se produce por el mero contacto entre el alimento y el suelo, siendo esos breves segundos suficientes para que las bacterias se adhieran y comiencen a multiplicarse. La advertencia de la doctora es clara: "Ahora ya sabes que lo que cae al suelo no se come".